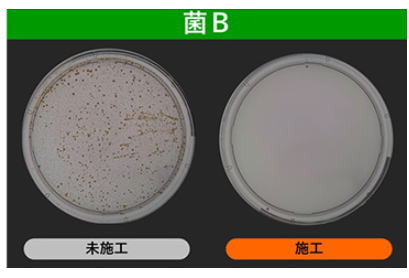

お掃除用品・お掃除サービスのことならダスキン下坂部支店。お掃除に関するさまざまなお困りごとを解決します。
TEL. 0120-649-244
〒661-0975 兵庫県尼崎市下坂部3丁目5-30
確かな技術と自由な発想 新しいライフスタイルをご提案します
接触頻度の高い箇所や天井・壁など対象面にあわせた2つの抗菌・抗ウイルス加工サービスをご提案します。
テーブル・手すり・取手などの硬質面には、抗菌・抗ウイルス効果のある薬剤を塗布するサービス。また、壁や天井には光触媒施工液を塗布、噴霧するサービス。2つのサービスを組み合わせることも可能です。

標準料金(施工対象面積合計20㎡まで)一律 33,000円(税込)
特長
---------------------------------------------------------------------------------------------

抗菌・抗ウイルス活性値2.0以上を確認
※試験上の結果であり、実際の施工環境によって効果は異なります。
※すべての菌・ウイルスに効果があるわけではありません。
----------------------------------------------------------
抗菌試験概要
試験方法:JIS Z 2801
試験対象:薬剤を塗布したステンレス片
試験結果:シャーレの写真
菌A 抗菌活性値5.3
菌B 抗菌活性値4.3
※試験上の結果であり、実際の施工環境によって効果は異なります。


抗ウイルス試験概要
試験方法:ISO 21702
試験対象:薬剤を塗布したステンレス片
試験結果:
エンベロープウイルス 抗ウイルス活性値3.2
ノンエンベロープウイルス 抗ウイルス活性値4.1
※試験上の結果であり、実際の施工環境によって効果は異なります。
--------------------------------------------------------------------

高耐久
水拭きしてもはがれにくい。(アルコール、中性・弱アルカリ性洗剤も使用できます。)
安心
コート表面から有害な物質は溶出しません。
※食品衛生法に基づく、合成樹脂製の器具または容器包装試験(合成樹脂一般規格)を実施。

室内の光(可視光)で抗菌※1※2・消臭効果(アンモニア)を発揮する
触媒なので、付着している限り効果が持続 ※2
天井や壁などに噴霧・塗布した光触媒は、室内の光で抗菌※1※2・消臭効果(アンモニア)を発揮し、素材に付着している限り効果が持続※2します。また、使用する薬剤に抗ウイルス効果※2※3もあります。
※1 JIS R1752に準じ、ガラスを試験片に500lx、24時間光を照射したときの効果。
※2 光を照射することで効果を発揮するため、暗所では効果は得られません。
※3 JIS R1756に準じ、綿布を試験片とし、500lx、4時間光を照射したときの効果。すべてのウイルスあるいは特定のウイルスに対する効果を保証するものではありません。また病気の予防や治療効果を示すものではありません。
※すべての菌・ニオイに効果があるわけではありません。




室内抗菌加工サービス(硬質面)
施工箇所が著しく汚れている場合は、別途料金が発生します。
吸水性の素材(紙・白木・繊維製品)・床材・畳・ゴム製品・液晶画面はお受けできません。
施工後1時間程度は触れないでください。1週間程度はあまり強い力で擦らないでください。
室内抗菌加工サービス(光触媒)
施工箇所が著しく汚れている場合は、別途料金が発生します。
硬質面・吸水素材(白木・紙)・金属・ゴム製品・皮革・畳はお受けできません。

※室内抗菌加工サービス(硬質面)は20㎡を超える場合は、20㎡ごとに33,000円(税込)追加
【サービスご利用にあたっての注意】
※商品・サービスは、予告なしにデザインや仕様、料金(価格)の変更や販売を中止することがございますので、ご了承ください。
※サービスは1回あたり11,000円(税込)以上で承ります。この料金は加盟店によって異なる場合があります。
※サービス実施日は時期によってご希望に添えない場合がございます。
※汚れによっては完全に除去できない場合がありますのでご了承くださいますようお願いいたします。
※サービスカーの駐車スペースのご用意をお願いします。駐車できない場合は有料駐車場を利用するため、駐車料金をご負担いただきます。
※一部対応できない地域・お店があります。
※渡船や連絡橋等の有料の移動手段を利用する場合は、実費を別途請求させていただきます。
※土・日・祝日のサービスに関しましては、お受けできないことがございます。
※洗剤などに含まれる化学物質で体調を崩したことのある方や、不安を感じられる方は、お店にお申し出ください。
光触媒についての説明
光触媒「ルネキャット®」について
こちらでは、ルネキャット®の技術情報(材料特性)についてご紹介しております。
実サービスでの効果ではありません。
室内抗菌加工サービス(光触媒)では、光触媒施工液に東芝マテリアル株式会社が開発した可視光応答型光触媒ルネキャット®(主成分:酸化タングステン)が採用されています。ルネキャット®は、タングステン※1の酸化物が持つ光触媒性能を活かし、室内光で抗菌効果を発揮します。
※1 元素記号W 金属元素の一つ。融点は3.000℃以上、沸点は5.500℃以上と耐熱性が非常に高い。
タングステンの酸化物は光触媒性能を発揮することが知られている。
※ルネキャット®は東芝マテリアル株式会社の登録商標です。
テーブル・手すり・取手などの硬質面には、抗菌・抗ウイルス効果のある薬剤を塗布するサービス。また、壁や天井には光触媒施工液を塗布、噴霧するサービス。2つのサービスを組み合わせることも可能です。

標準料金(施工対象面積合計20㎡まで)一律 33,000円(税込)
特長
---------------------------------------------------------------------------------------------
抗菌・抗ウイルス活性値2.0以上を確認
※試験上の結果であり、実際の施工環境によって効果は異なります。
※すべての菌・ウイルスに効果があるわけではありません。
----------------------------------------------------------
抗菌試験概要
試験方法:JIS Z 2801
試験対象:薬剤を塗布したステンレス片
試験結果:シャーレの写真
菌A 抗菌活性値5.3
菌B 抗菌活性値4.3
※試験上の結果であり、実際の施工環境によって効果は異なります。

抗ウイルス試験概要
試験方法:ISO 21702
試験対象:薬剤を塗布したステンレス片
試験結果:
エンベロープウイルス 抗ウイルス活性値3.2
ノンエンベロープウイルス 抗ウイルス活性値4.1
※試験上の結果であり、実際の施工環境によって効果は異なります。
--------------------------------------------------------------------

高耐久
水拭きしてもはがれにくい。(アルコール、中性・弱アルカリ性洗剤も使用できます。)
安心
コート表面から有害な物質は溶出しません。
※食品衛生法に基づく、合成樹脂製の器具または容器包装試験(合成樹脂一般規格)を実施。
室内の光(可視光)で抗菌※1※2・消臭効果(アンモニア)を発揮する
触媒なので、付着している限り効果が持続 ※2
天井や壁などに噴霧・塗布した光触媒は、室内の光で抗菌※1※2・消臭効果(アンモニア)を発揮し、素材に付着している限り効果が持続※2します。また、使用する薬剤に抗ウイルス効果※2※3もあります。
※1 JIS R1752に準じ、ガラスを試験片に500lx、24時間光を照射したときの効果。
※2 光を照射することで効果を発揮するため、暗所では効果は得られません。
※3 JIS R1756に準じ、綿布を試験片とし、500lx、4時間光を照射したときの効果。すべてのウイルスあるいは特定のウイルスに対する効果を保証するものではありません。また病気の予防や治療効果を示すものではありません。
※すべての菌・ニオイに効果があるわけではありません。




室内抗菌加工サービス(硬質面)
施工箇所が著しく汚れている場合は、別途料金が発生します。
吸水性の素材(紙・白木・繊維製品)・床材・畳・ゴム製品・液晶画面はお受けできません。
施工後1時間程度は触れないでください。1週間程度はあまり強い力で擦らないでください。
室内抗菌加工サービス(光触媒)
施工箇所が著しく汚れている場合は、別途料金が発生します。
硬質面・吸水素材(白木・紙)・金属・ゴム製品・皮革・畳はお受けできません。

※室内抗菌加工サービス(硬質面)は20㎡を超える場合は、20㎡ごとに33,000円(税込)追加
【サービスご利用にあたっての注意】
※商品・サービスは、予告なしにデザインや仕様、料金(価格)の変更や販売を中止することがございますので、ご了承ください。
※サービスは1回あたり11,000円(税込)以上で承ります。この料金は加盟店によって異なる場合があります。
※サービス実施日は時期によってご希望に添えない場合がございます。
※汚れによっては完全に除去できない場合がありますのでご了承くださいますようお願いいたします。
※サービスカーの駐車スペースのご用意をお願いします。駐車できない場合は有料駐車場を利用するため、駐車料金をご負担いただきます。
※一部対応できない地域・お店があります。
※渡船や連絡橋等の有料の移動手段を利用する場合は、実費を別途請求させていただきます。
※土・日・祝日のサービスに関しましては、お受けできないことがございます。
※洗剤などに含まれる化学物質で体調を崩したことのある方や、不安を感じられる方は、お店にお申し出ください。
光触媒についての説明
光触媒「ルネキャット®」について
こちらでは、ルネキャット®の技術情報(材料特性)についてご紹介しております。
実サービスでの効果ではありません。
室内抗菌加工サービス(光触媒)では、光触媒施工液に東芝マテリアル株式会社が開発した可視光応答型光触媒ルネキャット®(主成分:酸化タングステン)が採用されています。ルネキャット®は、タングステン※1の酸化物が持つ光触媒性能を活かし、室内光で抗菌効果を発揮します。
※1 元素記号W 金属元素の一つ。融点は3.000℃以上、沸点は5.500℃以上と耐熱性が非常に高い。
タングステンの酸化物は光触媒性能を発揮することが知られている。
※ルネキャット®は東芝マテリアル株式会社の登録商標です。
バナースペース
ダスキン下坂部支店
〒661-0975
兵庫県尼崎市下坂部3丁目5-30
TEL 0120-649-244